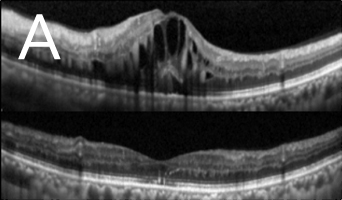

服务范畴
黄斑点病变治疗
黄斑病变的治疗新趋势
眼睛的视网膜就像摄影机的菲林一样,把影像的光线捕捉下来,然後把影像讯号传送至脑部。就结构而言,视网膜属於大脑的一部份,不能自行修复或进行移植。 视网膜的中央位置叫黄斑点,负责中央视力和颜色视力。所有黄斑点病都必须及早检查及治疗,否则後果严重,如出现中央视力模糊丶中央视野缺损或视物变形。当只有一只眼睛患病或病情进度缓慢时,部份患者可能并无徵状。医学界现时对黄斑病有更多了解,再加上先进临床仪器辅助,过往许多无法治愈的黄斑病,现时都能以手术治疗。
黄斑点穿孔治疗
黄斑点穿孔是指黄斑点中央的凹位失去视觉神经组织,此情况大多由於老化或深近视所致。治疗方法是施行扁平部玻璃状体切除术,移除凹前表质玻璃体,并进行气体和液体交换。大部份病人在手术後无须保持俯卧。患上黄斑穿孔的年长及深近视人士现时可以最新手术移除内界膜(图1)治疗,手术成功率超过90%。
黄斑点视网膜前膜增生之治疗
黄斑点视网膜前膜增生(图2)是本港常见眼疾之一,治疗方法包括切除玻璃体及移除前膜。采用内界膜去皮最新治疗能让患者的视力获得改善,而接受初次手术後复发率属低。
黄斑点裂损之治疗
近视超过600度的人士眼球拉长的情况非常严重,黄斑点亦被拉扯变薄。再加上不正常的玻璃体和黄斑点视网膜前膜增生之牵引,导致黄斑点神经组织裂开,甚至丧失视力。如未能及早施行适当治疗,黄斑点裂损有可能进一步恶化,导致黄斑点穿孔和黄斑点视网膜脱落。利用光相干性断层造影可及早发现并作出准确的诊断(图3)。治疗方法是施行扁平部玻璃状体切除术,移除凹前表质玻璃体,并进行气体和液体交换,治疗可治愈大部份病人的黄斑点凹位,而大部份病人在手术後亦无须保持俯卧。
老年性(图4)及深近视性(图5)黄斑点退化的脉络膜新生血管膜之治疗
光动力疗法曾经是老年性及深近视性黄斑点退化的脉络膜新生血管膜的主要治疗,惟此治疗仅可维持已衰退的视力,或遏止视力进一步退化。现时,眼内药物注射(包括Lucentis丶Avastin丶Eylea及类固醇)是常见治疗方法,能让大部份病人回复一定程度的受损视力。而且注射过程安全,甚少出现副作用。
眼睛的视网膜就像摄影机的菲林一样,把影像的光线捕捉下来,然後把影像讯号传送至脑部。就结构而言,视网膜属於大脑的一部份,不能自行修复或进行移植。 视网膜的中央位置叫黄斑点,负责中央视力和颜色视力。所有黄斑点病都必须及早检查及治疗,否则後果严重,如出现中央视力模糊丶中央视野缺损或视物变形。当只有一只眼睛患病或病情进度缓慢时,部份患者可能并无徵状。医学界现时对黄斑病有更多了解,再加上先进临床仪器辅助,过往许多无法治愈的黄斑病,现时都能以手术治疗。
黄斑点穿孔治疗
黄斑点穿孔是指黄斑点中央的凹位失去视觉神经组织,此情况大多由於老化或深近视所致。治疗方法是施行扁平部玻璃状体切除术,移除凹前表质玻璃体,并进行气体和液体交换。大部份病人在手术後无须保持俯卧。患上黄斑穿孔的年长及深近视人士现时可以最新手术移除内界膜(图1)治疗,手术成功率超过90%。
![]() 图1:手术期间的情况(从医生的角度望向患者左眼):利用眼内手术夹,在已形成的黄斑点穿孔(箭头所指位置)附近夹起内界膜(箭头所在位置)。 |
黄斑点视网膜前膜增生(图2)是本港常见眼疾之一,治疗方法包括切除玻璃体及移除前膜。采用内界膜去皮最新治疗能让患者的视力获得改善,而接受初次手术後复发率属低。
![]() 图2:深近视人士患上黄斑点视网膜前膜病变(手术前摄)。 |
黄斑点裂损之治疗
近视超过600度的人士眼球拉长的情况非常严重,黄斑点亦被拉扯变薄。再加上不正常的玻璃体和黄斑点视网膜前膜增生之牵引,导致黄斑点神经组织裂开,甚至丧失视力。如未能及早施行适当治疗,黄斑点裂损有可能进一步恶化,导致黄斑点穿孔和黄斑点视网膜脱落。利用光相干性断层造影可及早发现并作出准确的诊断(图3)。治疗方法是施行扁平部玻璃状体切除术,移除凹前表质玻璃体,并进行气体和液体交换,治疗可治愈大部份病人的黄斑点凹位,而大部份病人在手术後亦无须保持俯卧。
![]() ![]() 图3:光相干性断层造影(OCT):(A)发现大量黄斑点裂损,并有视网膜黄斑点凹位脱落迹象,且在黄斑点凹位附近发现不正常的玻璃体牵引(箭头所指位置)。(B)手术後六个月黄斑点裂损的情况大有改善,减少视网膜黄斑点脱落的幅度。 |
老年性(图4)及深近视性(图5)黄斑点退化的脉络膜新生血管膜之治疗
光动力疗法曾经是老年性及深近视性黄斑点退化的脉络膜新生血管膜的主要治疗,惟此治疗仅可维持已衰退的视力,或遏止视力进一步退化。现时,眼内药物注射(包括Lucentis丶Avastin丶Eylea及类固醇)是常见治疗方法,能让大部份病人回复一定程度的受损视力。而且注射过程安全,甚少出现副作用。
![]() 图4:老年性黄斑点退化-出血 |
![]() 图5:深近视性黄斑点退化 |